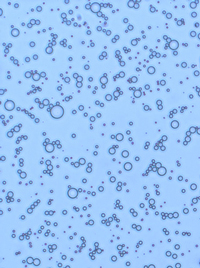

Microbubble Ultrasound Contrast Agents
Microbubble Ultrasound Contrast Agents
Microscopic image of microbubble
contrast agents.
Ultrasound contrast agents are suspensions of gas-filled microbubbles that are currently used to enhance the capabilities of diagnostic imaging. Microbubble contrast agents are also providing new avenues for therapeutic applications of ultrasound in areas such as gene transfection, drug delivery, and thrombolysis. Ongoing research in the Dalecki lab focuses on developing an understanding of the physical and biological mechanisms for the interaction of ultrasound fields with tissues containing microbubble contrast agents.

Experimental studies investigate ultrasound-induced bioeffects of microbubble contrast agents in the cardiovascular system. Contrast agents provide a direct means to study acoustic cavitation in vivo. Working with our collaborators provides unique capabilities to computationally simulate the dynamic responses of microbubbles to sound exposure within a confining blood vessel. Results of this work will provide insight into the nonlinear bubble dynamics that can occur within blood vessels, and help to facilitate the advancement of microbubble contrast agents in both diagnostic ultrasound imaging and therapeutic applications.
This line of research has been funded by the National Institutes of Health (NIH) and the National Science Foundation (NSF).
Project Collaborator: